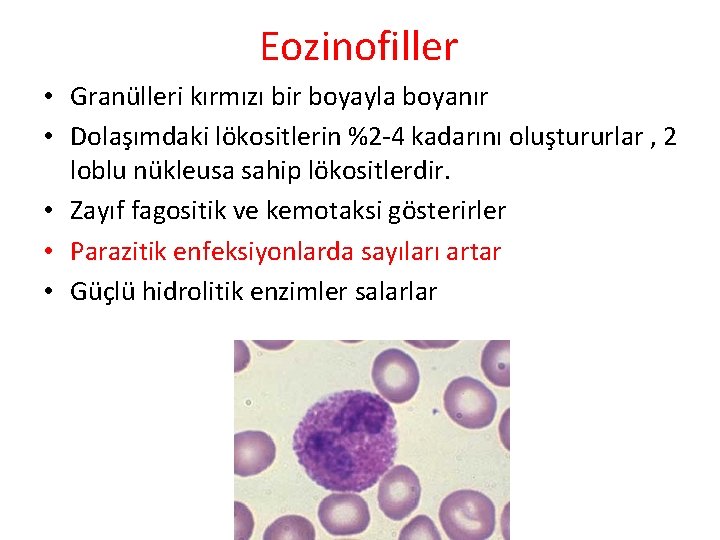
Eozinofiller • Granülleri kırmızı bir boyayla boyanır • Dolaşımdaki lökositlerin %2 -4 kadarını oluştururlar

r Gr Emine KILI TOPRAK Kann Kompozisyonu KAN













































































































- Slides: 109

Öğr. Gör. Emine KILIÇ TOPRAK

Kanın Kompozisyonu KAN PLAZMA Plazma proteinleri KAN HÜCRESİ Serum Albumin Eritrosit su Trombosit Granüler Lökosit Agranüler Lökosit Nötrofil Lenfosit tuz Glubulin Eosinofil Çözünmüş gaz Fibrinojen Pıhtılaşma faktörü Lökosit hormonlar Monosit Basofil Glikoz Atık maddeller

KANIN GÖREVLERİ 1. Taşıma görevi; oksijen, karbondioksit, besinler, atık ürünler 2. Düzenleme görevi; hormonlar ve ısı 3. Koruma-Savunma görevi; Lökositler 4. Kanamayı durdurma görevi; Pıhtılaşma mekanizması

Taşıma Görevi • Hücreler ile dış ortam arasında madde taşır. – Sindirilmiş besinlerin dokulara taşınması – Enzimlerin taşınması – Metabolik artıkları hücrelerden alarak dışarıya atılacağı veya zararsız hale getirileceği organlara (böbreklere, karaciğere, akciğerlere ve ter bezlerine) taşır. – O 2 ve CO 2’nin dokulara ve solunum organlarına taşınması – Hormonların salgılandığı yerden hedef organa taşınması – Isının dışarı yayılacağı yüzeylere taşınması

Düzenleme Görevi • Pıhtılaşmayla kanamayı durdurur. • Kanın deriye akımının artması ya da azalmasıyla vücut ısısını ayarlar • Asit baz dengesinin düzenlenmesinde görev alır. • Kan taşıdığı tampon bileşiklerle p. H’ın korunmasına yardımcı olur. • Optimum vücut sıcaklığını 36 -37 o. C, p. H’ı 7, 357, 45 arasında tutar • Vücudun iç dengesinin korunmasını sağlar

Koruma Görevi • Bileşiminde bulunan çeşitli proteinler, antikorlar ve lökositlerle mikroorganizmalara ve organizmanın kendine yabancı bulduğu her çeşit etkene karşı organizmayı korur. • Vücuda giren yabancı maddelerin (virüs ve bakteriler) fagosite edilmesi ve antikorlarla zararsız hale getirilmesi için ortam oluşturur (Lökositler)

Kanamayı Durdurma Görevi • Enzim ve kan pulcuklarıyla (trombosit) kanın pıhtılaşmasını sağlayarak kan kaybını önler

• Dolaşımdaki kan hacmi, vücut ağırlığının ~%7 -8’i kadar • Erişkin bir erkekte 5 -6 litre kadında ise 4 -5 litre kan bulunur bu farklılık daha çok vücut ağırlığıyla ilgilidir. İnsanda vücut ağırlığının yaklaşık %7’si kandır. Yani vücut ağırlığı 70 kg olan bir kişide yaklaşık 5 litre kan bulunur. • Kan hacminin normal oluşuna normovolemi, az oluşuna hipovolemi, fazla oluşuna hipervolemi adı verilmektedir. (yaş, cinsiyet, vücut tipine göre farklı) – %80’i sistemik dolaşımda • %75 venöz • %15 arteryel • %10 kapiller – %20’si pulmoner dolaşımda • %46 venöz • %46 arteryel • %7 kapiller

Fiziksel özellikleri • Rengi kırmızı – açık-koyu • Hafif tuzlu • Yağ asitlerinden dolayı özel kokulu • Sıcaklığı 38 o. C • p. H – 7. 35 -7. 45 • E; 5 -6 lt, K; 4 -5 lt

Hematokrit: kandaki hücrelerin % miktarıdır. Sağlıklı erkeklerde % 40 -49 kadınlarda ise % 37 -47 oranında bulunur. Kanın santrifüj edilmesiyle özel çizelgeler yardımıyla okunur. Eritrositler, en altta ve en kalın tabaka olarak, Lökositler, ortada daha ince bir tabaka olarak görülür.


Kanın Yapısı *PLAZMA (%55) Su, protein, yağ, glikoz, aminoasit, eriyik tuzlar, vs… *KAN HÜCRELERİ (%45)

KAN PLAZMASI • Hacminin, %90 -92` si su, geriye kalanın çoğunluğunu plazma proteinleri oluşturur. • Aminoasitler, karbonhidratlar, yağlar, tuzlar, potasyum, kalsiyum, magnezyum, klorit, anorganik iyot, hormonlar, enzimler, üre, ürik asit, laktik asit ve antikorlar

Plazmanın Bileşimi Su %90 -92 tüm diğer elemanların taşıyıcı ortamı Elektrolitler Sodyum Potasyum Kalsiyum Magnezym Klor Bikarbonat Fosfat Sülfat > %1 145 m. M 4 m. M 2. 5 m. M 1, 5 m. M 103 m. M 24 m. M 1 m. M 0, 5 m. M suyu ekstrasellüler kompartmanda tutar, tampon olarak etki eder, membranın uyarılabilirliğinde ve kan pıhtılaşmasında görev alırlar

Plazmanın Bileşimi-2 Proteinler albumin globulin fibrinojen Gazlar karbondioksit oksijen nitrojen %7, 3 g (2, 5 m. M) %4, 5 g %2, 5 g %0, 3 g tampon olarak etki eder, diğer plazma elemanlarını bağlar ve taşır, pıhtılaşma faktörleri, enzimler, enzim prekürsörleri, antikorlar, hormonlar olarak rol oynar %2 ml (1 m. M) %0, 2 ml (0, 1 m. M) %0, 9 ml (0, 5 m. M) Øbir atım ürünüdür Øoksidatif metabolizma Øfonksiyon yok

Plazmanın Bileşimi-3 Besinler glikoz amino asitler lipidler (total) kolesterol vitaminler eser elementler %100 mg (5, 6 m. M) %40 mg (2 m. M) %500 mg (7, 5 m. M) %150 -200 mg (4 -7 m. M) %0, 0001 -2, 5 mg (0, 00005 -0, 1 m. M) %0, 001 -0, 3 mg (0, 0001 -0, 1 m. M) Atık ürünler üre (protein) kreatinin (kreatin) ürik asit (nükleik asitler) bilurubin (hem) %34 mg (5, 7 m. M) %1 mg (0, 09 m. M) %5 mg (0, 3 m. M) %0, 2 -1, 2 mg (0, 0001 -0, 01 m. M) Hormonlar %0, 000001 -0, 05 mg (10 -9 -10 -8 m. M)

Plazma Proteinleri • Kan hacminin % 55’i plazmadır. Plazma hacminin de %92’si sudur. Ortalama olarak 100 ml plazmada 7. 6 gr protein vardır ve üç ayrı sınıfa ayrılırlar. • Plazmada bulunan proteinler onkotik basınç oluştururlar. • Onkotik basınç doku ile kapiller damarlar arasındaki sıvı alışverişinde önemli rol oynar. • Plazma proteinlerinin oluşturduğu onkotik basınç sıvının damar içine geri alınmasını sağlar.

Albümin • Plazma proteinlerinin % 60’ını temsil ederler. • Damar duvarında ozmotik (onkotik) basınç yaratır. • Albümin konsantrasyonu düştüğünde damar dışına sıvı geçişi olur. Buna ödem denir. • Krc’de yapılır • Taşıyıcı; – Yağ asitleri – Hormonlar – Bilirübin – Enzim – ilaç

Regulation of colloidal pressure Gaw: Clinical Biochemistry; Churchill Livingstone (1999), p. 44.

Globülin • Plazma proteinlerinin % 36’sı • Taşıyıcı ve immünglobulinler diye ikiye ayrılır. • 3 tipi vardır 1 - Gama globulinler • immunoglobulinler – antikor (Ab) 2 - Alfa ve Beta globulinler (taşıyıcı) • Alfa ve beta globulinler lipidleri ve yağda eriyen vitaminleri kanda taşırlar. • transport globulinler – Demir taşıyan transferrin – Hormon-bağlayıcı (tiroid H) – Apolipoproteinler (yağlar) – Steroid-bağlayıcı (testosterone)

Fibrinojen • Plazma proteinlerinin % 4’ü • Kanın pıhtılaşmasında rol alır • Plazmadan pıhtı uzaklaştırılırsa = serum. • Belli şartlarda fibrin denilen ipliksi yapılara dönüşürler. Fibrinojen fibrine dönüştüğünde plazmadan geri kalan sıvıya serum adı verilmektedir


Serum ve Plazmanın Farkı? ? Serum da kanın sıvı kısmıdır. Ancak serum kan pıhtılastıktan sonra olusan sıvı kısmıdır. Serumun plazmadan farkı, serum içerisinde fibrinojenin bulunmamasıdır. Serum elde edilmesi için kana herhangi bir madde ilave etmeksizin pıhtılasması beklenir ve ardından dinlendirilerek yada santrifüj edilerek pıhtının (hücresel kısım) dibe çökmesi saglanır.

1. Alyuvarlar (Eritrositler) • Kan hücrelerinin % 50`sini oluştururlar. • Taşıdıkları hemoglobinden (15 g/dl) dolayı kırmızı renktedirler • 1 mm 3 kanda – erkeklerde 5 – 5. 5 milyon – kadınlarda 4. 5 – 5 milyon • Ort çapları 7 -8 mikrometre • Kalınlıkları 2, 5 mikrometre, merkezde 1 mikrometre • Ort hacimleri 90 -95 fl • Tüm omurgalılarda yükseklere çıkıldıkça kandaki sayıları artar

• Bu yapı şekli eritrositlerin yüzey alanının genişlemesine ve 4 µm gibi çok dar kapillerlerden geçebilmelerine olanak sağlar. • Mitokondri ve DNA gibi pek çok organeli içermezler. Mitokondri olmadığından enerji ihtiyaçları için aldıkları glukozu oksijensiz olarak yıkarlar böylece dokular için taşıdıkları oksijeni maksimum oranda ihtiva ederler

ERİTROSİTLER (Kırmızı Kan Hücreleri-Alyuvarlar) • Hemoglobin taşıyan çekirdeksiz ve organelsiz hücrelerdir. • İki tarafı içbükey diskler şeklinde • Alyuvarlar kılcal damarlardan geçerlerken şekillerini önemli ölçüde değiştirebilirler • Ömürleri 120 gün kadardır. • Her bir eritrosit 280 milyon hemoglobin molekülü içerir • Karbonik anhidraz enzimini içerir -fazla miktarda CO 2, kandaki H 2 O ile tepkimeye girer ve HCO 3 halinde Akc’lere taşınır-

Hemoglobin • globulin + hem • Her bir molekül Hb 4 molekül oksijen taşır • O 2 taşıyan Hb • CO 2 taşınımına yardım eder

HEMOGLOBİN • Eritrosit içindeki proteinin en büyük kısmını oluşturur % 95 oranında • kanla taşınan oksijenin % 98’i bu moleküle bağlı olarak taşınır • Eritrosit hacminin yaklaşık üçte birini hemoglobin – K 14 gr/dl – E 16 gr/dl • Hemoglobin molekülü hem ve globin moleküllerinin 4’er tanesinin bir araya gelmesiyle oluşur. • Hem molekülünün yapısında bulunan demir oksijeni bağlar – 1 gr Hb, 1, 34 ml O 2 bağlar – Normalde her desilitrede erkekte 21 ml kadında 19 ml oksijen taşınabilir. • Hemoglobin oksijenle gevşek ve geri dönüşümlü olarak bağlanır. • Hemoglobin hidrojeni bağlayarak asit baz dengesini düzenler.

Eritrositlerin esas fonksiyonu akciğerlerden dokulara oksijeni ileten hemoglobini taşımaktır.


HEMATOPOEZ • Eritrositlerin üretimi: • embriyonik yaşamın ilk birkaç haftasında primitif çekirdekli eritrositler vitellus kesesinde, dalak, karaciğerde • Gebeliğin 2. trimesteri sırasında esas olarak karaciğer, dalak ve lenf düğümlerinde

• Gebeliğin son ayı ve doğumdan sonra ise kemik iliğinde • 5 yaşına kadar tüm kemiklerin ilikleri • 20 yaş üzerinde humerus ve tibanın proksimal bölümleri dışında uzun kemiklerin ilikleri yağlanır ve eritrosit yapımı durur. Bu yaştan sonra eritrosit yapımı vertebralar, sternum, kostalar ve iliak kemik gibi kemiklerin iliklerinde devam eder. • Yaş arttıkça ilik daha az üretken olur. • Yetişkin bir insanda eritrositler, lökositlerin çoğu ve trombositler kemik iliğinde oluşur.

Kan hücrelerinin oluşma ve farklılaşma evreleri

Retikülositte, Hb oranı yüksektir (yaklaşık %80 kadar) Nükleus yoğunlaşarak küçülür Endoplazmik retikulum vardır Az miktarda golgi kalıntısı, mitokondri ve sitoplazmik organeller içerir. Retikülositler kemik iliğinden diapedez yoluyla (kapiller membranın porlarından sıkışarak) kana geçerler. Retikülositlerdeki bazofilik materyal 1 -2 günde kaybolur ve olgun retikülosit haline dönerler.

Eritrosit üretiminin temel düzenleyicisi olarak doku oksijenlenmesi: Dokulara taşınan oksijen miktarının azalmasına neden olan her koşul eritrosit üretim hızını arttırır. Havadaki oksijen miktarının büyük oranda azaldığı çok yüksek yerlerde dokulara yetersiz oksijen taşınır ve bu eritrosit yapımının artmasına neden olur.

• Eritrosit üretimini arttıran esas faktör dolaşımdaki yaklaşık 34. 000 molekül ağırlığındaki glikoprotein olan eritropoietin hormonudur. • Normal kişilerde tüm eritropoiteinin yaklaşık % 90’ı böbreklerde geri kalanı karaciğerde sentezlenir. Bu hormon eritroblastları oluşturan kök hücrelerinin ve eritroblastların bölünmesini uyarır. Ayrıca hemoglobin sentezini de arttırarak fonksiyonel eritrositlerin oluşmasına neden olur. • Eritrositlerin olgunlaşma evrelerinde ise vitamin B 12 ve folik asit önemli iki vitamindir. Bu vitaminlerin eksikliğinde Megaloblastik anemi oluşur.

• Eritrositlerin yıkımı: Eritrositler kemik iliğinden dolaşıma çıktıkları zaman yıkılmadan önce ortalama 120 gün dolaşımda kalırlar. • Eritrositler yaşlanmaya başladıkça metabolik sistemleri giderek daha az aktif hale gelir ve yaşamsal olayları zayıfladığı için hücre daha kırılgan olmaya başlar. • Ayrıca bu süre boyunca çeşitli mekanik streslere maruz kaldıklarından fonksiyonel özellikleri kaybolmaya başlar. • Bu durumda yıkılmalarına ve yenilerinin sentezine gerek vardır. • Eritrosit membranı kolayca zedelenebilir hale geldiği zaman dolaşımdaki dalak gibi bazı dar noktalardan geçerken eritrositler yırtılır ve yıkılır (hemoliz) veya buradaki fagositoz yapan hücreler yaşlı eritrositleri tanır ve hemoliz olmadan önce onları fagositoza uğratarak (yutarak) ortadan kaldırır. • ayrıca bu fagositoz olayı karaciğer ve kemik iliğindeki bazı özel hücrelerce de gerçekleştirilir.


Demir metabolizması

Demirin Barsaktan Emilimi

Hematokrit Erkekte: % 44 -46 Kadında: % 40 -42

Sedimantasyon: Pıhtılaşmasına engel olunmuş kanın eritrositlerinin rulo formu oluşturarak para yığınları şeklinde çökme hızlarına denir. Westergren (200 mm dereceli pipet) adı verilen bir aletle ölçülmektedir. Erkek: 3 -8 mm /saat Kadın: 7 -12 mm / saat

ESH (Alyuvar çökme hızı) • ESH'ın azaldığı durumlar: . Polisitemi • ESH'ın arttığı durumlar: • . Enfeksiyon hastalıkları globulin artışı. Doku yıkımı hastalıkları fibrinojen artışı Tümörler. Verem. Romatizmal ateş. Romatoid artrit. Bağ doku hastalıkları. Glomerülonefrit. Miyokard enfarktüsleri

• Anemi= Kansızlık • • • Sebepleri: Demir eksikliği (en sık) Kan kaybı Eritrosit yapım bozuklukları Eritrositlerin yapısındaki bozukluklar nedeniyle normal yaşam sürelerinden önce dolaşımdan yıkılarak uzaklaştırılmaları • Aneminin tersi duruma ise polistemi adı verilir.

Anemiler • Kan kaybı anemisi • Aplastik anemi Kurşun, x ısınlarına maruz kalma • Megaloblastik anemi B 12 vit Folik asit İntrinsik faktör • Hemolitik orak anemi hücre anemisi(sickle cell anemi) Talasemi Akdeniz anemisi; hemolitik anemi (Hb’deki alfa veya beta zincirlerinden biri eksik)

Polisitemi • Sekonder polisitemi Hipoksi Dolaşım bozuklukları Akciğer hastalıkları yüksek yer • Poisitemi vera » Gen anormalliği, viskozite artar

• Kan grupları • Eritrosit membranında özellikleri kalıtımla belirlenen özel yapıda glikoproteinler veya glikolipitler bulunur. Bunlara yüzey antijeni denmektedir. • Bu antijenlere aynı zamanda aglutinojen de denmektedir. • A, B ve D (Rh) antijenleridir. • Bunlara göre A, B, AB ve O olmak üzere 4 ana kan grubu bulunur. • A grubu kanda sadece A aglutinojeni • B grubu kanda sadece B aglutinojeni • AB grubu kanda sadece AB aglutinojenleri bulunurken • O grubu kanda hiç aglutinojen bulunmamaktadır.

• Aglutinin: Bunlar plazmada bulunan ve yabancı eritrositler ile antijenlere saldıran moleküller (antikorlar)dir. • A grubu kanda anti-B aglutinin’i • B grubu kanda anti-A aglutinin’i • O grubu kanda hem anti-A hemde anti-B aglutinin’leri bulunurken • AB grubu kanda ise anti-A ve anti-B aglutininleri bulunmamaktadır. • Aglutinin + Aglitinojen = Aglutinasyon = Hemoliz.

Kan grupları Genotipler Kan grubu Aglütinojenler Aglütininler Antijen Antikor 00 0 ---- 0 A veya AA A A Anti A ve Anti B 0 B veya BB AB B B Anti A AB A ve B ----


Rh kan grupları • 6 tip Rh faktörü vardır • C, D, E ve c, d, e • Tip D en yaygınıdır


Eritroblastozis fötalis (Yeni doğanın hemolitik hastalığı) • Baba Rh + • Anne Rh – • Bebek Rh + Bebek babasından Rh (+) antijeni alır, anne bebeğin Rh antijeni ile karşılaştıktan sonra anti. Rh aglütininler geliştirir. Plasentadan geçen bu aglutininler fetusun kanında eritrosit aglutinasyonuna yol açar. 1. gebelikte genellikle annede bebeğe zarar verecek ölçüde aglutinin yapılamaz. Gebelik sayısı arttıkça risk artar.

Yeni doğanın hemolitik hastalığı • Fetüs doğumda anemiktir. • Ölüm nedeni genellikle ağır anemidir. • Hızlı üretim nedeniyle periferde çekirdekli blastik hücreler vardır. • Kern ikterus: Bilirübinin bebeğin bazal ganglionlarında depolanmasıyla kalıcı mental bozukluklar yada beynin motor bölgelerinin hasarı.

Kan uyuşmazlığına bağlı transfüzyon reaksiyonları • Vericinin kanındaki aglutinojen önemlidir. • Örneğin, A grubundaki bir kişiye B grubu kan verilecek olursa vericinin eritrositlerindeki B aglutinojeni ile alıcının plazmasındaki anti-B aglutininin reaksiyonu sonucu aglutinasyon ve hemoliz gelişir. • Hemolizin şiddetine bağlı olarakta sarılık gözlenebilir.

Lökositler • Organizmanın savunma sisteminin hareketli elemanlarıdır. • Organizmayı bakterilere, virüslere, parazitlere ve tümörlere karşı savunurlar • Patojenlere karşı vücudu korurlar ve toksinler ile artık maddeleri temizlerler • 4000 – 11000 mm 3 arasında değişebilir. • <4000 ise lökopeni, • >11000 ise lökositozis denilmektedir. • Lökositoz enfeksiyon belirtisidir.

LÖKOSİTLER 1) Granülositler 2) Agranülositler • Granülositler ; nötrofiller, eozinofiller ve bazofiller olmak üzere 3 ayrı tipe ayrılır • Agranülositler ; monosit, lenfosit ve plazma hücreleri olmak üzere 3 ayrı tipe ayrılır • Granülositlerde sekresyon vezikülleri ile lizozomlar bulunur.

• Lökositlerin Özellikleri • Lökositler dolaşımdan hasarlı dokuya veya yabancı organizmaların istila ettiği yapılara kolaylıkla geçerler. Dolaşımdaki lökositler başlıca özellikleri şöyle sıralanabilir. • Ameboid hareket yapabilirler. Bu hareketlerde hücre iskeletlerinin aktin ve miyozin mollekülleri rol oynar ve ATP harcanır. Bundan dolayı kan damarlarından diapedez yoluyla çevredeki dokuya geçebilirler. • Belli kimyasal maddelere doğru hareket edebilirler. Kemotaksi denen bu özelliklerinden dolayı istilacı organizmalar, artık ve ölü organizmalara ulaşabilirler.


Lökositler Granüllü lökositler % Nötrofiller 50 -70 Eozinofiller 1 -4 Bazofiller 0 -1 Agranüler lökositler Monositler 2 -8 Lenfositler 20 -40


Bazofiller • Bazik boyalarla boyanan çok sayıda mavi veya mor granül içerirler. • Çok nüleusludurlar ve çapları 8 -10 mikron kadardır. Dolaşımdaki lökositlerin % 1’inden azını (0. 6) oluştururlar. • Heparin, histamin, bradikinin ve seratonin salarlar • Allerjik reaksiyonlarda önemli rol oynarlar
Eozinofiller • Granülleri kırmızı bir boyayla boyanır • Dolaşımdaki lökositlerin %2 -4 kadarını oluştururlar , 2 loblu nükleusa sahip lökositlerdir. • Zayıf fagositik ve kemotaksi gösterirler • Parazitik enfeksiyonlarda sayıları artar • Güçlü hidrolitik enzimler salarlar

Nötrofiller • Dolaşımdaki lökositlerin % 50 -70’i nötrofildir. • Olgun bir nötrofilin çekirdeği 2 -5 segmentlidir. • Bu yüzden polimornükleer lökositler olarak da isimlendirilirler. • Hasarlı dokuya ilk ulaşan lökositlerdir. • Kanda 4 -8 saat, dokuda 4 -5 gün yaşarlar • Enfeksiyon bölgesine hızla giderler • Fagositik özellikler kuvvetlidir • Proteolitik enzim içeren bol miktarda lizozom içerirler • Akut bakteriyal enfeksiyonlarda sayıları artar

GARFİELD KURALLARI 1. Canlılar yorgun doğar, dinlenmek için yaşar. 2. Çalışmak yorar. 3. Yarın yapabileceğin işi bugün yapma. 4. Bugünün işini yarına bırakma, erteleyebileceğin kadar ertele. 5. Dinlenen birini görünce, ona eşlik et. 6. Oturmak mümkünse ayakta durma, yatmak mümkünse oturma. 7. Çalışma isteği gelince, hemen bir yere otur ve geçmesini bekle. 8. Tembellikten kimse ölmemiş.

AGRANÜLOSİTLER • MONOSİTLER • LENFOSİTLER

Monositler • Dolaşımdaki lökositlerin % 2 -10’unu oluştururlar. Çapı 15 µm olan böbrek şeklinde çekirdek ihtiva eden hücrelerdir. Bir monosit kan dolaşımında 24 saat kadar kaldıktan sonra periferdeki dokulara geçer ve makrofaj adını alır • Kanda aktif değiller, doku düzeyinde güçlü fagositik özellik kazanırlar • Örneğin; kupffer hücreleri, histiyositler, alveolar makrofaj, osteoklast, mikroglia gibi. • Monositler ve makrofajlar da aktif fagozitoz yeteneğine sahip hücrelerdir.

Nötrofil ve Makrofajların özellikleri • Diapedez • Kemotaksi • Fagositoz

Lenfositler • Sinir dokusu hariç her türlü dokuda bulunurlar. • İnce bir sitoplazma var • Kemik iliğinde meydana gelirler. • Lenf düğümleri ve diğer lenfoid dokulardan lenfatik drenaj ile sürekli dolaşıma katılırlar • Birkaç saat sonra diyapedez ile, dokulara geçerler; sonra tekrar lenfe girerler ve kana geri dönerler • Bu nedenle yaşam süreleri, vücudun gereksinimine göre haftalarca veya aylarca olabilir • Çoğu bağışıklık işlevinde kullanılırlar.

Vücudun Enfeksiyonlara Direnci bağışıklık ve alerji

Vücudun Enfeksiyonlara Direnci bağışıklık ve alerji Doğal bağışıklık -akyuvar makrofaj sistemi - mide asidi ve sindirim enzimleri - deri - kandaki bazı kimyasal ajanlar

• Edinsel bağışıklık - İmmun sistem tarafından üretilen antikor ve aktif lenfositler - Aşılama

• Lenfositler: Eritrosit büyüklüğünde ve koyu boyanan hücrelerdir. • Dolaşımdaki lökositlerin % 20 -30’u lenfosittir. • T ve B lenfositleri diye iki ayrı tipi bulunmaktadır.

• B LENFOSİTLER – HUMORAL BAĞIŞIKLIK • Antikor üretimi • T LENFOSİTLER – HÜCRE-ARACILI BAĞIŞIKLIK – SİTOTOKSİK – Virüs, bakteri ve kanser hücrelerine karşı uzun-süreli koruma – Effektör T hücreleri, Tefektör , bağışıklık sistemi baskılanınca etki eder – Yardımcı T hücreleri; T HELPER B hücrelerini aktive eder – Baskılayıcı T hücreleri; T SUPRESOR, B hücre aktivitesini inhibe eder – Bellek hücreleri; T BELLEK, aynı antijenle ikinci kez karşılaşınca uyarılır

B lenfosit • Humoral immüniteden sorumludurlar. • Aktiflenen B hücreleri plazma hücrelerine dönüşürler. • Plazma hücrelerinden salgılanan antikorlar vücuttaki yabancı hücrelere veya dokulara saldırırlar Hemapoetik kök hücreden köken alırlar - Karaciğer ve kemik iliğinde üretilirler

Plazma hücreleri • Bir antijenle karşılaştıklarında, B lenfositler antikorları sentezleyen plazma hücrelerine dönüşürler • Normal olarak bulunmazlar. kanda

• Lökosit Üretimi ve Düzenlenmesi • Lökosit üretimi temel olarak kemik iliğindeki kök hücreden yapılmaktadır. Nötrofil eozinofil ve bazofil gelişmesi kemik iliğinde tamamlanır. • Monositlerin farklılaşması kemik iliğinde başlar sonra dolaşıma oradan da dokulara geçerek makrofaj haine dönüşürler. • Lenfositler ise yine kemik iliğinde yapılır fakat olgunlaşmaları için timus, dalak ve lenf düğümleri gibi periferik lenfoid dokulara göç ederler.

Kan hücreleri

Lösemi • Dolaşım kanında anormal akyuvar sayısının çok artmasıdır • Lenfoid lösemi lenf düğümünden kaynaklı • Miyeloid lösemi kemik iliğinden kaynaklı

Antikorlar • Ig G, insanda en çok bulunur • Ig E, alerjide önemlidir • Ig M, • Ig A • Ig G

Aşılama • Ölü organizmalarla (boğmaca, difteri, tifo) • Toksik özelliğini kaybetmiş ancak antijenik özelliğini kaybetmemiş toksinlerle (tetanus, botilism) • Zayıflatılmış canlı aşılar (çocuk felci, kızamık, suçiçeği, tbc)


Trombositler (Kan Pulcukları) • Yuvarlak oval 2 -4 mikron çaptalar • Megakaryositlerden oluşurlar • Kanda 150 -300 bin/ mm 3 kadar bulunurlar • Nukleusları yoktur, çoğalmazlar • Sitoplazmalarınada aktin, miyozin gibi kontraktil elemanları vardır • Bol kalsiyum depolarlar • Sitoplazmalarında başka bir çok aktif madde bulundururlar

• Trombositler (Plateletler) • Normalden az olmalarına trombositopeni, çok olmalarına trombositoz denir. • Üretim yerleri kemik iliğidir. Buradaki megakaryosit denen dev hücrelerden sentez edilmektedirler. • Görevleri: • Pıhtılaşmada gerekli olan kimyasal maddeleri taşımak • Hasara uğrayan kan damarı çeperlerinde geçici tıkaç oluşturmak. • Pıhtı oluşumundan sonra kasılarak pıhtının çapını ve damar çerindeki hasarın çapını azaltmak


• Trombositler Şişerler ve düzensiz şekil alırlar, sayısız psödöpotlar uzatırlar Kasılarak içlerindeki aktif maddeleri salarlar Adezyon Agregasyon

Damar Hasarı Endotelial mediatörler Vazokonstriksiyon Trombosit adhezyonu Trombosit agregasyonu Doku faktörü Plazma faktörleri Vasküler Faz Geçici Trombosit Fazı tıkacı Fibrin Plazma Fazı

• Damar Spazmı Kan kaybının azalması Sinirsel refleksler (ağrı vb uyaranlar ile) Lokal miyojenik spazm** Doku ve trombosit kaynaklı lokal humoral faktörler (Küçük damarlarda trombosit kaynaklı TXA 2) Damar ne kadar çok zedelenirse spazm derecesi o kadar büyük olur. Dakikalar, saatler Trombosit tıkacı oluşumu, koagülasyon

Trombosit tıkacı oluşumu Damardaki hasar küçükse kan pıhtısı yerine sadece trombosit tıkacı ile kapatılır. 1. Trombositler v. WF sentezler 2. ADP, seratonin salınır, trombosit agregasyonu gerçekleşir 3. Tromboxan A 2 ve PAF , TIKAÇ oluşturan maddeler

Trombosit agregasyonu

Damar hasarı büyükse kan pıhtısı oluşur • 1 -2 dk içinde pıhtılaşma başlar • 3 -6 dk’da pıhtı tamamlanır • 20 -60 dk’da pıhtı büzüşür

Pıhtılaşma Mekanizması 1. Protrombin aktivatörünün oluşması 2. Oluşan protrombin aktivatörünün Ca 2+ iyonlarının beraberliğinde protrombinden trombin oluşturması 3. Trombinin fibrinojene etki ederek fibrin ipliklerini oluşturması. Fibrin iplikleri kan hücrelerini ve plazmayı içine alarak bir kitle oluşturur, buna pıhtı adı verilmektedir.

• Pıhtılaşma 3 ana basamakta meydana gelir: • A) Protrombin aktivatörü oluşumu Ca++, trombosit • B) Protrombin Trombin (Proteolitik enzim) Ca++ • C) Fibrinojen Fibrin monomeri • Fibrin Stabilize edici Fibrin iplikçikleri Plazma globulinleri faktör (XIIIa) • Çapraz bağlı Fibrin iplikçikleri • Protrombin aktivatörü oluşumu hız sınırlayıcı basamak


• Protrombin aktivatörü 2 yolla oluşur: • 1) Damar duvarı ve çevresindeki dokuların travmaya uğramasıyla başlayan ekstrensek yol • 2) Kanın kendi içinde başlayan intrensek yol

• Pıhtılaşma ekstrensek ve intrensek sistemlerin aynı anda aktivasyonu ile başlatılır. • Ekstrensek yol patlayıcı bir şekilde oluşur. • İntrensek yol daha yavaş gelişir. • Pıhtı oluştuktan sonra birkaç dakika içinde kasılmaya başlar. [Pıhtının retraksiyonu (büzüşmesi) ] Pıhtı retraksiyonunda trombositler önemli rol oynar. Pıhtı içindeki sıvının çoğu ayrılır (serum). • Pıhtı retraksiyonu ile damar uçları birbirine yaklaştırılır Hemostazın son aşaması


Pıhtı Fibroblastlarca bağ dokusuna dönüştürülür Enzimatik etki ile pıhtı eritilir. Pıhtının bağ dokusuna dönüştürülmesinde trombositlerden salgılanan büyüme faktörünün de etkisi vardır. Pıhtının tümüyle fibröz dokuya dönüşmesi 1 -2 hafta sürer.


Normal Damar Sisteminde Pıhtılaşmanın önlenmesi (Intravasküler Antikoagülanlar) Klinik Kullanımda Antikoagülanlar • • • Endotele ait faktörler • 1)Endotelin düzgünlüğü • 2)Glikokaliks tabakası • 3) Trombomodulin • • Protein C • Heparin Kumarin Sitratlı bileşikler EDTA t-PA Urokinaz Streptokinaz

Kan damar içinde neden pıhtılaşmaz? ? ? • Normal koşullar altında • Antikoagülanlar Prokoagülanlar Damar zedelendiğinde Prokoagülan aktivasyonu Pıhtı oluşumu

Kan Pıhtılaşma Testleri • Kanama Zamanı 1 -6 dk • Pıhtılaşma zamanı 6 -10 dk • Protrombin zamanı 12 sn

Pıhtının Erimesi Yaralanan Doku Alfa-2 Antiplazmin Doku Plazminojen Aktivatörü (t-PA) Plazminojen (Profibrinolizin) Plazmin (Fibrinolizin) Pıhtının Erimesi, Faktör V, VIII, Protrombin, Faktör XII’nin sindirilmesi

• Hemostaz Bozuklukları • Kan damarlarında aşırı pıhtı oluşmasına Trombüs denir. • Kanda serbestçe dolaşan pıhtılara emboli adı verilir. • Hemofili pıhtılaşma faktörlerinin yetmezliği ile meydana gelen genetik bir hastalıktır.


Kanama bozuklukları Koagulasyon - hemofilia A ve B Platelet bozuklukları - Trombositobenia Kapillar frajilite - Vitamin C eksikliği - Kalıtsal hemorajik bozukluklar

Hemophilia A • Genetik Faktor VIII eksikliği • X bağlıdır. Sadece erkeklerde görülür • 1: 10, 000

